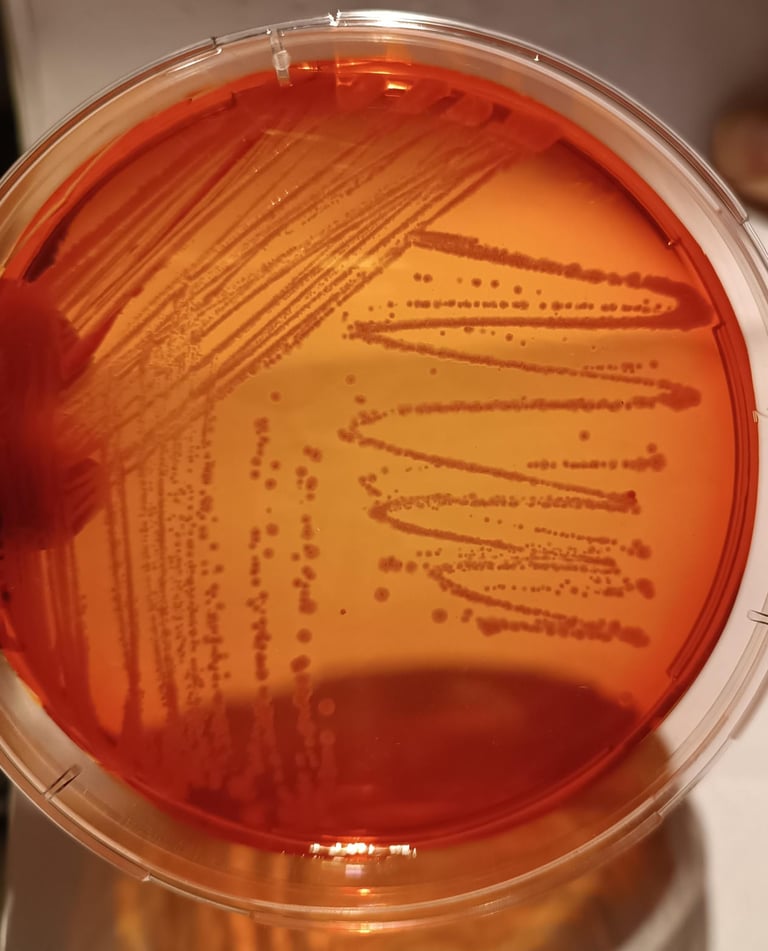
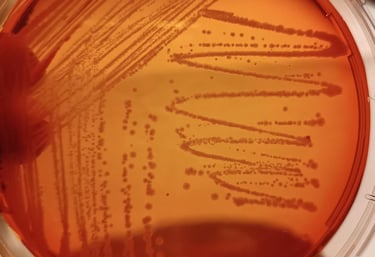

Biológicos que mejoran el rendimiento del cultivo y regeneran el suelo
Desarrollamos y fabricamos biofertilizantes y biocontroladores que optimizan la nutrición del cultivo, fortalecen la planta y mejoran la salud del suelo.
Clientes 100% satisfechos
★★★★★
Fabricamos nuestros propios productos
En Campo Biológico desarrollamos y producimos nuestros insumos microbiológicos, lo que nos permite garantizar calidad, consistencia y adaptación a diferentes sistemas productivos.

Asesoramiento técnico directo basado en el funcionamiento real de nuestros microorganismos en el campo.
Biofertilizantes
Nutrición inteligente desde la biología
Los biofertilizantes aportan microorganismos beneficiosos que mejoran la disponibilidad de nutrientes, estimulan el desarrollo radicular y potencian el crecimiento del cultivo de forma natural.
Optimizan la eficiencia del suelo y reducen la dependencia de insumos químicos.
Biotak P


Contiene bacterias del género Pseudomonas (PGPR).
Favorece la solubilización del fósforo.
Promueve un crecimiento radicular.
Ayuda al estrés climático.


Ecotak Az
Formulado con Azospirillum.
Fija nitrógeno atmosférico y de la
rizósfera.
Promueve el crecimiento vegetal (PGPR).
Su base principal es el lombricompuesto.
Estimula el desarrollo vegetal (PGPR).
Mejora la estructura del suelo y la disponibilidad de nutrientes
Ecocrop


Bioestimulante con micronutrientes
Solubilizador de fósforo mineral
Fijador biológico de nitrógeno
Certificaciones
Calidad que se ve en el campo
Trabajamos con procesos rigurosos y trazables, respaldados por un equipo técnico especializado en microbiología y producción biológica.
Cada uno de nuestros desarrollos está pensado para ofrecer resultados consistentes, maximizando la eficiencia productiva sin comprometer la salud del suelo.
Operamos bajo estándares exigentes de calidad y control, asegurando productos confiables, estables y alineados con las nuevas demandas de una agricultura más sustentable.


Biocontroladores
Protección natural con precisión biológica
Los biocontroladores utilizan microorganismos para combatir plagas y enfermedades de manera efectiva, segura y sustentable.
Actúan directamente sobre los agentes dañinos sin afectar el equilibrio del ecosistema ni la salud del cultivo.


Ecotak Bt
A base de Bacillus thuringiensis israelensis y Bacillus thuringiensis svar. kurstaki.
Controla eficazmente plagas.
Seguro para el ambiente y los organismos benéficos.
Biotak B
Su principal componente es Bacillus subtilis.
Actúa como fungicida natural.
Previene y controla enfermedades fúngicas en los cultivos.
PGPR


Control biológico de hongos
Insecticida biológico
Muchos suelos producen menos porque perdieron biología
La intensificación agrícola ha reducido la actividad microbiológica del suelo.
Esto genera:
• menor disponibilidad de nutrientes
• mayor estrés del cultivo
• más susceptibilidad a enfermedades
• menor eficiencia productiv
Los bioinsumos permiten recuperar la actividad biológica del suelo y mejorar la eficiencia del sistema productivo.


Nosotros
CAMPO BIOLÓGICO S.A.S.
inició su camino en el año 2003.
Desde entonces, trabajamos con un propósito claro: producir insumos que promuevan una agricultura más sustentable y amigable con el medio ambiente.


Nuestra Misión
Comprometidos con la sustentabilidad.
Desarrollamos productos biológicos innovadores, que combinan ciencia y naturaleza para mejorar el rendimiento de los cultivos, cuidando los recursos del suelo y del entorno.



